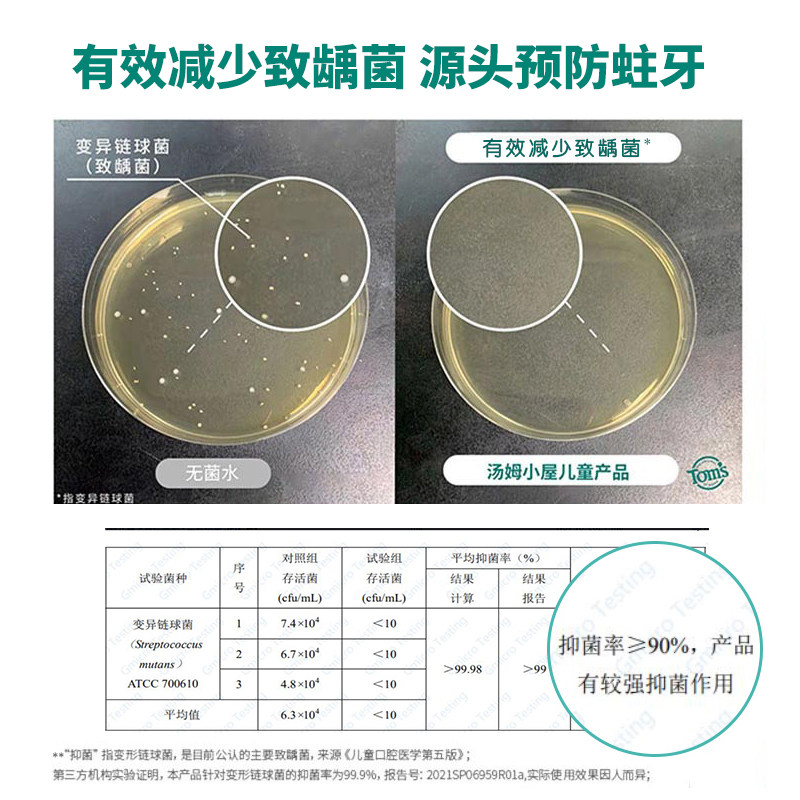

已售 0
汤姆小屋Toms儿童牙膏3到6 12岁2岁以上宝宝专用含氟防蛀草莓正品
所 在 地:湖北 武汉
累计销量:0 件
领券优惠: 30元券
店铺掌柜: 汤姆小屋洗护旗舰店
商品标签:
¥49.9 ¥125.00
商品详情